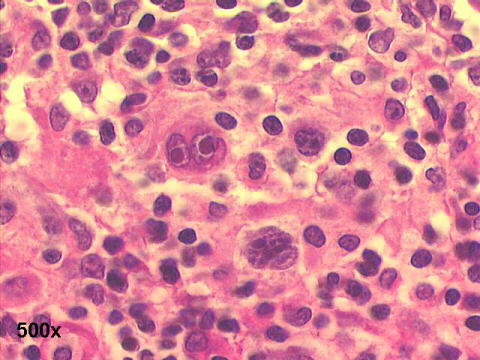
Reed-Sternberg cell 500x H&E staining

Features of HodgkinÇs disease (HD)- Romanowsky stains
Cellular patterns:
Polymorphic lymphoid cell population; "lymphoglandular bodies" in the background
Reed-Sternberg (R-S) cells: classic binucleated, with mirror-image nuclei. HodgkinÇs cells: mononuclear cell. Few multinucleated/polyploid cells.
Cytoplasm:
Small amount of pale basophilic cytoplasm in R-S cells
Some cells have small cytoplasmic vacuoles
Nucleus
R-S cells: two large, hyperchromatic, mirror-image
R-S cells: each nucleus has a large macronucleolus. In Papanicolaou or H&E staining, with a clear halo around the nucleoli
Mitoses, karyorrhexis and apoptotic bodies may be found
Phenotypic markers:
Classic R-S cells and its variants are CD15+ and CD30+, CD45-, CD20-
Lymphocyte-predominant HD is CD15-, CD30-, and CD45+
Caveat: FNA primary diagnosis of HD should be confirmed by surgical biopsy!